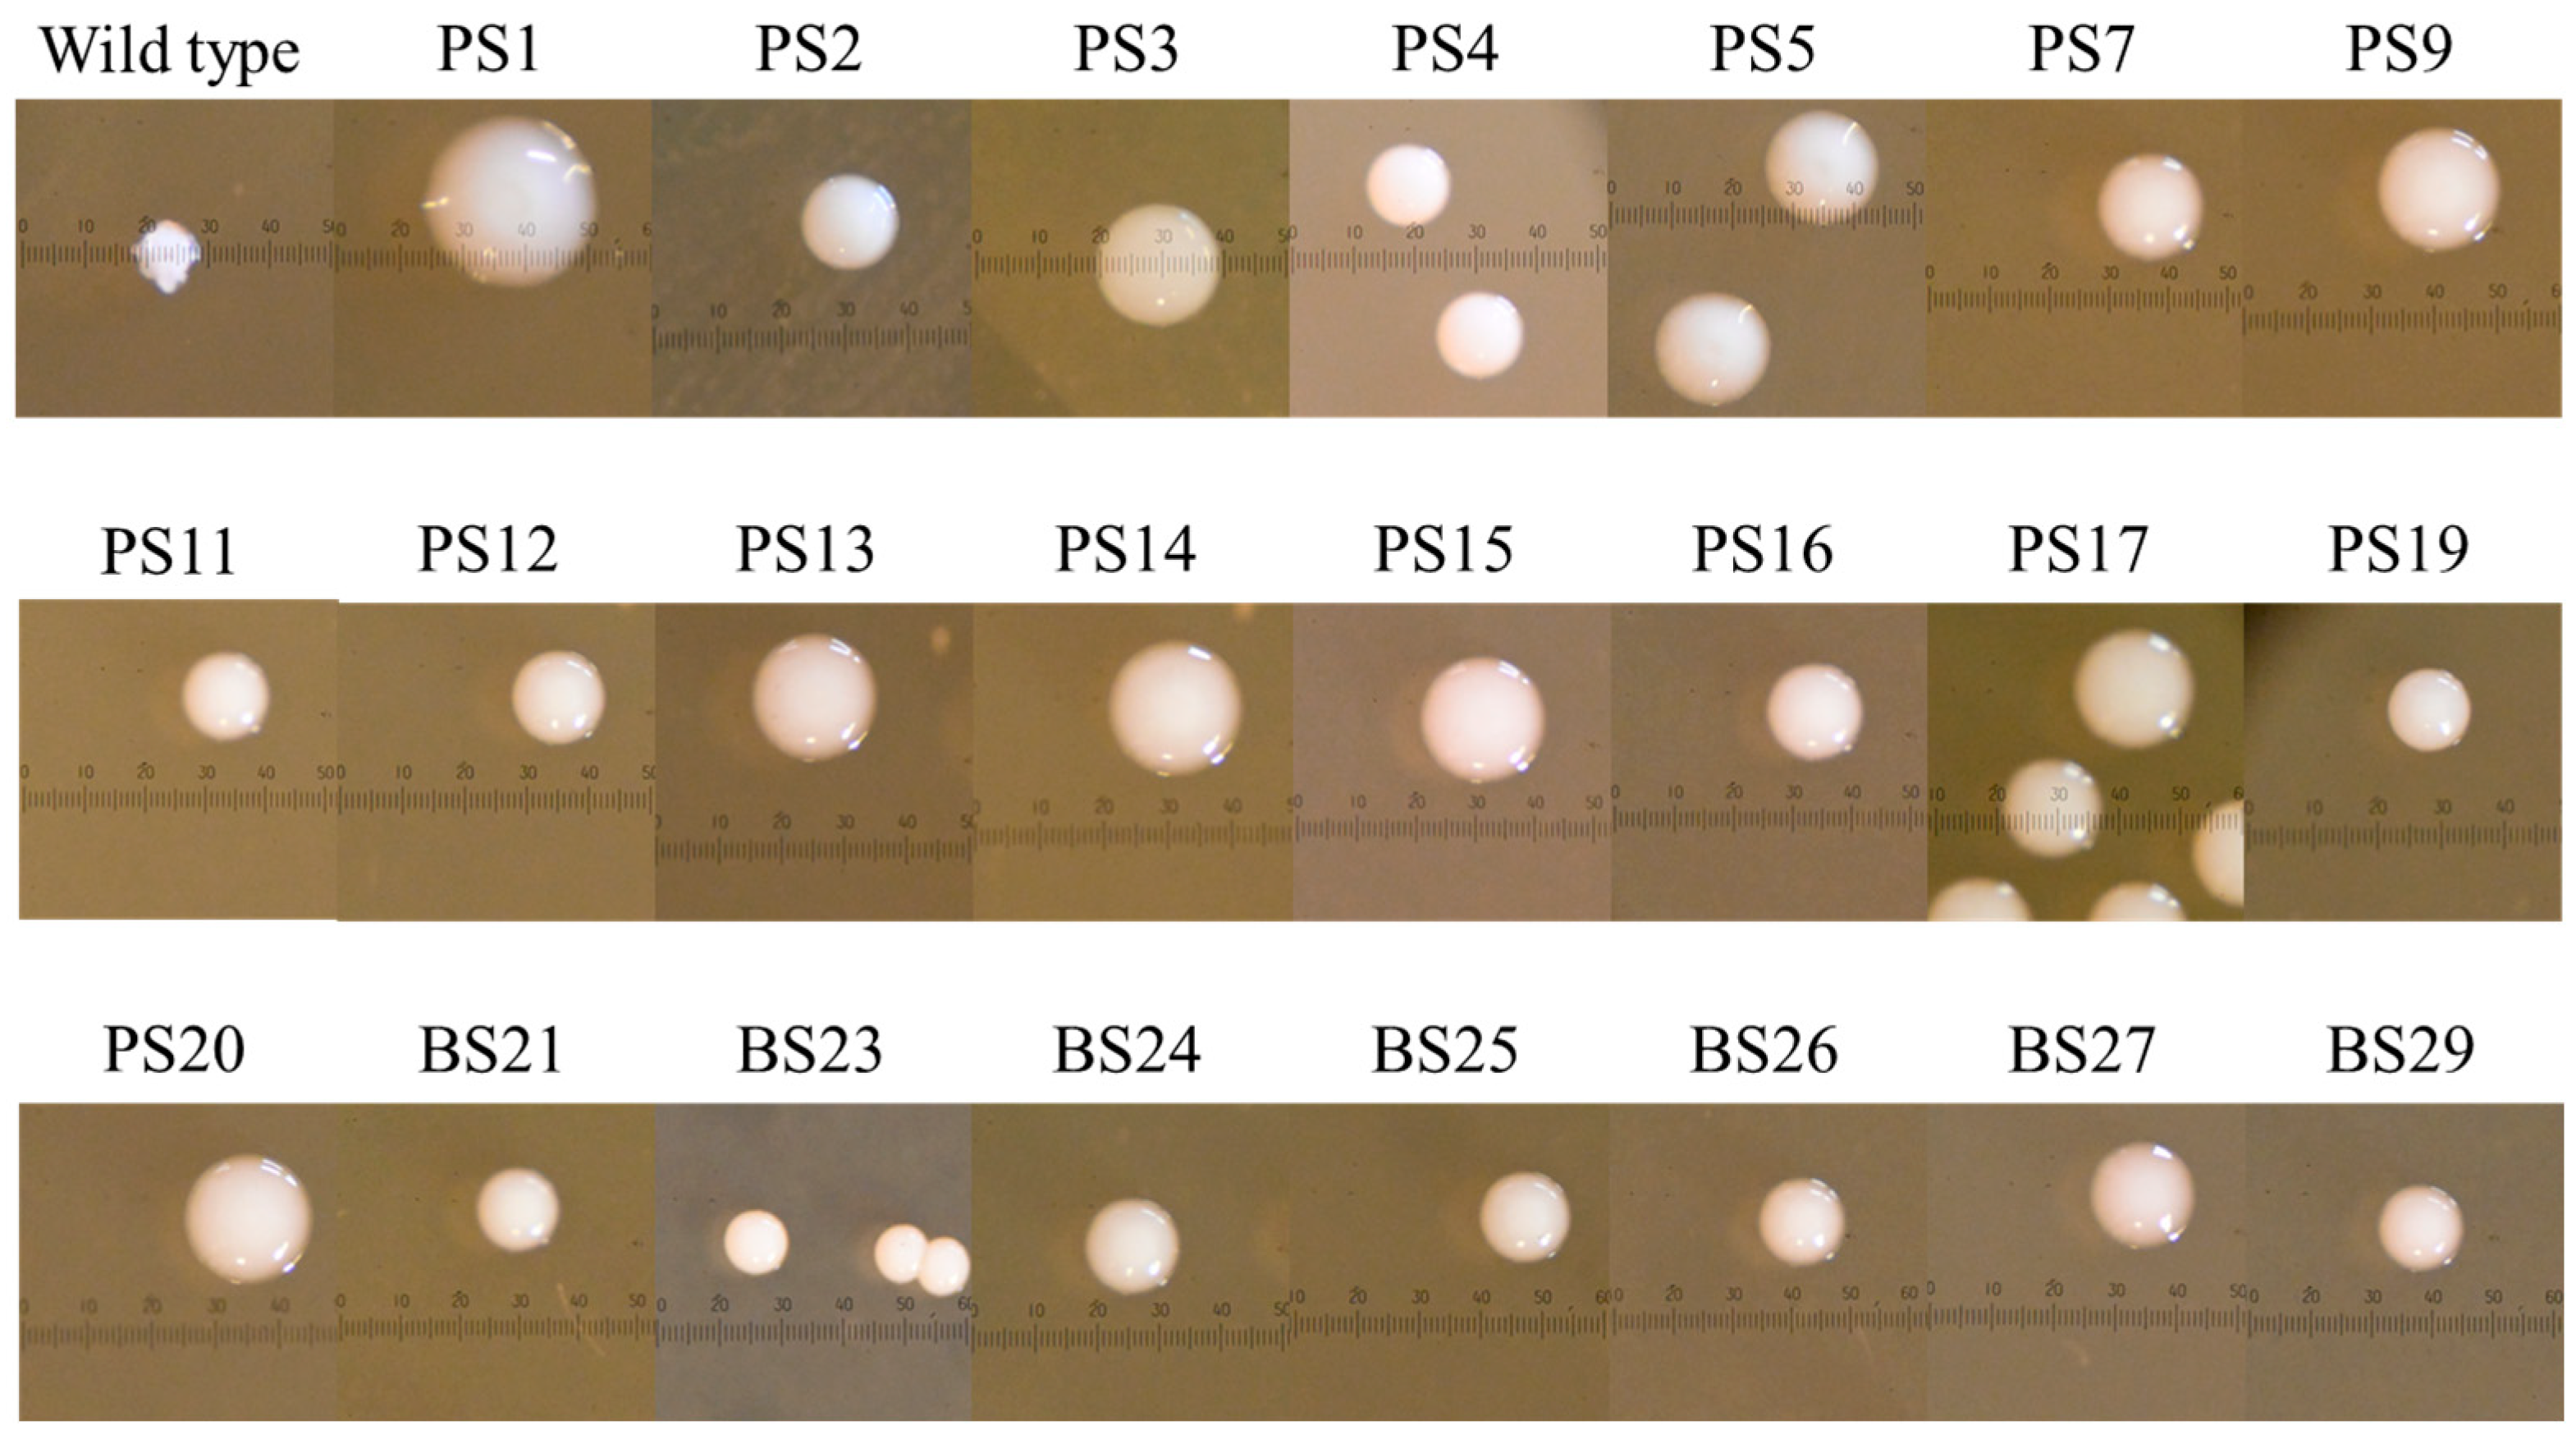
Bacteria 03 00025 g001

Abstract
Streptococcus mutans is primarily found in biofilms on tooth surfaces and is associated with the development of dental caries. S. mutans synthesizes water-insoluble glucan (WIG) using sucrose as a substrate, inducing the formation of three-dimensional biofilms. WIG is produced by glucosyltransferases (GTFs) encoded by the tandem and highly homologous gtfB and gtfC genes. Conversely, the homologous recombination of gtfB and gtfC readily happens, producing natural variants without WIG. These WIG− variants are thought to have ecologically pleiotropic functions; however, the molecular basis for their appearance is unclear. This study aimed to determine the sequence of the gtfB–gtfC regions of WIG− variants. We sequenced the gtfB–gtfC regions of 23 WIG− variants derived from S. mutans UA159 and revealed the presence of five alleles and four types of single homologous recombination patterns. Regardless of the allele type, the WIG− variants showed low biofilm formation and GTF activity. To the best of our knowledge, this is the first study to report the presence of alleles in WIG− variants. These findings provide important information for explaining the appearance of mechanisms in WIG− variants.
1. Introduction
Streptococcus mutans, a Gram-positive facultative anaerobic bacterium, is mainly found in biofilms on tooth surfaces, known as dental plaque. S. mutans can transport and metabolize a wide range of carbohydrates and grow at a low pH. S. mutans uses sucrose as a substrate to synthesize glucan, which serves as an integrated scaffold for biofilm formation and facilitates the local accumulation of microbial cells [1]. The presence of glucan also restricts the dispersion of S. mutans, allowing it to remain on the tooth surface for a long time. Although dental caries is a polymicrobial disease, S. mutans is its major cause.
Three glucosyltransferases (GTFs), GftB, GtfC, and GtfD, are responsible for glucan synthesis in S. mutans. These enzymes are thought to originate via transposon-mediated horizontal gene transfer from lactic acid bacteria and Leuconostoc [2]. Additionally, GTFs are thought to have undergone intragenomic gene duplication due to secondary selection pressure from sugar consumption. Of the three GTFs of S. mutans, GtfB and GtfC are involved in water-insoluble α1,3-glucan (WIG) synthesis, which strongly influences biofilm formation [3]. Since gtfB and gtfC are highly homologous in tandem, they frequently undergo homologous recombination [4,5,6]. The resulting WIG− variants are expected to lose oral adaptability because of their reduced biofilm-forming ability [6]. However, the presence of WIG− strains may have multiple effects. WIG− strains exhibited a higher growth rate in a sucrose-supplemented medium than wild-type strains [7]. Nomura et al. [8] detected the presence of S. mutans with a reduced biofilm formation ability after gtfB and gtfC recombination in human heart valve tissue. WIG− variants may also be involved in the survival and development of microorganisms in their environmental niche [6]. However, the molecular basis for their appearance and the ecological significance of WIG− variants remain to be elucidated.
This study aimed to determine the molecular basis of the appearance of WIG− variants. To clarify this, the gtfB–gtfC region of 23 WIG− variants obtained from S. mutans UA159 was sequenced.
2. Materials and Methods
2.1. Bacterial Strains and Culture Conditions
Brain heart infusion (BHI) medium (Becton Dickinson and Company, San Jose, CA, USA) was used for bacterial growth. Tryptic soy broth without dextrose (TSB) medium (Becton Dickinson and Company) was used to assess biofilm formation. Wild-type S. mutans UA159 (ATCC700601), a naturally derived WIG− variant, and the gtfBC mutant [6] were cultured at 37 °C in a 5% CO2 atmosphere. Escherichia coli DH5α was used for cloning and plasmid amplification.
2.2. Isolation of WIG− Variants from Liquid Cultures
A colony of S. mutans UA159 on BHI agar was inoculated into liquid BHI medium and grown for two days. Bacterial cells were suspended in phosphate-buffered saline (PBS; pH 7.4), serially diluted, and plated on BHI agar supplemented with 0.25% (w/v) sucrose. After the plates were cultured for two days, colony morphology was confirmed under an SZ40 stereomicroscope (Olympus Medical System Co., Ltd., Tokyo, Japan). Smooth-type colonies were picked from the plates and cultured in liquid BHI medium for two days. Finally, the cells were suspended in 15% (v/v) glycerol and stored at −70 °C.
2.3. gtf Cloning and Sequencing
Genomic DNA was extracted from the cells using ISOPLANT (Nippon Gene Co., Ltd., Tokyo, Japan), according to the manufacturer’s protocol. The PCR mix for gtf amplification was prepared by mixing 10 µL PrimeSTAR Max Premix (2×) (Takara Bio Inc., Shiga, Japan), 50 ng genomic DNA, gtfB-186F (5′-TTGGAGGTTCCTAATGGAC-3′) and gtfC-9269R (5′-GAAATTTACAGCTCAGACTTC-3′) primers (a final concentration of 1.25 µM each), and PCR-grade water. The amplification conditions were as follows: 30 cycles at 98 °C for 10 s, 55 °C for 10 s, and 72 °C for 2 min. The purified PCR fragment was ligated into a pGEM®-T vector (Promega, Madison, WI, USA) using the Mighty TA cloning reagent set for PrimeSTAR (TaKaRa Bio, Shiga, Japan). E. coli DH5α was plated on BHI agar supplemented with ampicillin (Wako Pure Chemical Industries, Osaka, Japan), 5-bromo-4-chloro-3-indolyl-β-d-galactopyranoside (X-Gal; Wako Pure Chemical Industries), and isopropyl-β-d-thiogalactopyranoside (IPTG; Wako Pure Chemical Industries) for blue–white screening. The inserted sequence was confirmed by sequencing using a BigDye Terminator v3.1 kit (Life Technologies Corporation, Carlsbad, CA, USA) and 16 primers (Supplementary Table S1) using a 3730xl DNA Analyzer (Thermo Fisher Scientific, Waltham, MA, USA). The sequences were aligned using ClustalW alignment and GENETYX ver.17 (GENETYX Co., Tokyo, Japan). Phylogenetic analyses of allele frequencies were performed using the unweighted pair group method with arithmetic mean (UPGMA) method in the Molecular Evolutionary Genetics Analysis (MEGA; www.megasoftware.net/, accessed on 11 September 2024, The Biodesign Institute, Tempe, AZ, USA)-11 software. Similarity spots were analyzed using GENETYX ver. 17.
2.4. Biofilm Formation Assessment
Biofilm formation was measured by monitoring cell adherence to 96-well polystyrene microtiter plates (Sumitomo Bakelite, Tokyo, Japan) prepared according to the protocol reported by Nakamura et al. [9], with some modifications. Briefly, aliquots of an S. mutans overnight culture (2 μL) and 100 μL of 2× TSB medium supplemented with 0.5% sucrose were added to each well of the microtiter plates, and sterile distilled water was added to a volume of 200 μL. The plates were then incubated at 37 °C in a 5% CO2 atmosphere for 20 h. After incubation, the microtiter plates were washed with distilled water, and the adherent cells were stained with 0.01% (w/v) crystal violet. The dye was solubilized in 33% (v/v) acetic acid solution, and the A590 was determined using a microplate reader (Colona Electric; Ibaraki, Japan).
2.5. Isolation of WIG− Variants from Biofilms
Biofilms formed by wild-type UA159 cells were used to obtain the WIG− variants. The biofilms formed on the microtiter plates were washed with PBS (pH 7.4), resuspended in 200 μL of PBS, and disrupted with a handheld ultrasonic homogenizer (UR-21P; Tomy Digital Biology Co., Ltd., Tokyo, Japan) at 6 W for 20 s. The cell suspension was serially diluted and plated on BHI agar containing 0.25% (w/v) sucrose. The subsequent procedures were performed as outlined in Section 2.2.
2.6. Measurement of GTF Activity
The GTF-containing fraction was prepared according to the protocol described by Goto et al. [10]. Briefly, to prepare the GTF fraction, S. mutans UA159 cultures grown in BHI medium were centrifuged at 8000× g for 10 min at 5 °C. The supernatant was subjected to ammonium sulfate (Fujifilm Wako Pure Chemicals Co., Ltd., Osaka, Japan) precipitation at 60% saturation at 4 °C for 3 h. After salting, the mixture was centrifuged at 9390× g at 4 °C for 30 min, and the precipitated proteins were dissolved in 0.1 M PBS (pH 7.4). The obtained solution was dialyzed >100-fold in 0.1 M PBS for 3 h using a cellulose dialysis membrane (molecular weight of 12,000–14,000) (Viskase Companies Inc., Lombard, IL, USA). After dialysis, ultrafiltration was performed on a 100 kDa ultrafiltration filter (Amicon® Ultra-100K, Merck, Darmstadt, Germany). The resulting >100 kDa fraction was suspended in 0.1 M PBS (pH 7.4) and concentrated 60-fold. The protein content of the crude enzyme solutions was determined using a protein assay kit (Thermo Fisher Scientific), with bovine serum albumin as the standard. Glucan production capacity was defined as the amount of insoluble saccharide synthesized by the crude enzyme solution with sucrose as a substrate at 37 °C for 1 h.
2.7. Statistical Analysis
The data on biofilm formation and GTF activity are expressed as the mean ± standard deviation. These data were analyzed using the Tukey–Kramer method for post hoc group comparisons (p < 0.05).
3. Results
3.1. Isolation and Characterization of WIG− Variants
Colony morphology was used as the criterion for the WIG− phenotype. Colonies of wild-type S. mutans showed a hard and rough morphology on sucrose agar medium, whereas the naturally derived WIG− variants showed a smooth morphology [7]. We obtained 16 and 7 WIG variants from the S. mutans UA159 liquid cultures and biofilms, respectively (Figure 1 and Table 1). The gtfB (old_locus_tag: SMU.1004) and gtfC (old_locus_tag: SMU.1005) genes of S. mutans UA159 are tandem sequences that are 4431-bp- and 4368-bp-long, respectively, and contain a 196 bp spacer region between them (NCBI accession: CP101984.1). We then amplified the 5′ flanking region of gtfB and the 3′ flanking region of gtfC via PCR using DNA obtained from each cell as a template. The wild-type strain showed gene amplification bands at approximately 9000 and 4300 bp, whereas all 23 WIG variants showed a single gene amplification band at 4300 bp (Figure 2).

Figure 1.
Colony morphology of Streptococcus mutans UA159 wild-type and WIG− variants grown on BHI agar plates supplemented with 0.25% sucrose. The scale bars in the image represent mm.

Table 1.
WIG− strains used in this study.

Figure 2.
Amplification of the gtfB and gtfC regions in Streptococcus mutans UA159 wild-type and WIG− variants. Lane M, Gene Ladder Wide 1 (Nippon Gene, Co., Ltd.).
The PCR products of the gtfB–gtfC region of each variant introduced into the plasmid vector were sequenced via a double-stranded analysis using 17 different primers. The sequence was deposited in the DNA Data Bank of Japan under the accession numbers LC832132 to LC832154 (Table 1). After multiple alignments with ClustalW, using the MEGA-11 software, each sequence showed the presence of five alleles (allele types I to V). Allele type I had a length of 4290 bp and was the most common sequence, with 16 variants. The type III allele had a length of 4291 bp, and one strain harbored this allele. Types II, IV, and V had lengths of 4290 bp, corresponding to the two strains, respectively. Table 2 shows the similarities between the allele types. The highest similarity (99.95%) was observed between allele types IV and V, while the lowest similarity (99.04%) was observed between allele types II and V (Table 2). The homology values between gtfB and types I to V were 89.79%, 89.48%, 89.72%, 90.39%, and 90.44%, respectively. The homology values between gtfC and types I to V were 88.97%, 89.14%, 88.90%, 88.37%, and 88.32%, respectively.

Table 2.
Identity matrix (%) among allele types.
3.2. Allele Patterns of the gtf Region in WIG− Variants
The positions of the alleles in the nucleotide sequences of the gtfB–gtfC gene regions among the WIG− variants were determined via a similarity spot analysis (Figure 3 and Figure 4). Alleles were found at 42 positions in the 4291 bp sequence. Alleles were particularly concentrated at nucleotide positions 1701 to 1773 and 2691 to 2976, with 10 sites in the former and 28 sites in the latter. The type I allele was based on the gtfB sequence and was identical to the sequence of gtfC after nucleotide position 2691. The type II allele was based on the gtfB sequence and was identical to the sequence of gtfC after nucleotide position 1701, with alleles identified at nucleotide positions 2043, 2100, and 2109. The type III allele was similar to the type I allele, except for alleles at nucleotide positions 2100 and 2109 and an insertion at nucleotide position 3392. The type IV allele was based on the gtfB sequence and was identical to the sequence of gtfC after nucleotide position 2973. The type V allele was based on the gtfB sequence and was identical to the sequence of gtfC after nucleotide position 3123.

Figure 3.
Similarity plots. DNA sequences were aligned with ClustalW, and a similarity plot was generated using GENETYX ver. 17. The numbers on the x-axis and in the figure represent nucleotide positions.

Figure 4.
Allele positions in the WIG− variants. The numbers in the figure represent the nucleotide positions. Yellow highlights indicate agreement with the nucleotides of gtfB, blue highlights indicate agreement with the nucleotides of gtfC, and green highlights indicate agreement with neither gtfB nor gtfC.
3.3. Biofilm Formation and GTFs Activity of WIG− Variants
The ability of the obtained WIG− variants to form biofilms in the presence of sucrose was examined (Figure 5). The results showed that all variants had a significantly poorer biofilm formation ability than the wild-type strain and were comparable to the gtfBC mutant. In addition, the assessment of the GTF activity of the crude purified fraction from the culture medium revealed that each WIG− variant had a significantly lower GTF activity than the wild-type strain, comparable to the gtfBC mutant (Figure 6). These results suggest that, regardless of allele type, WIG− variants have a low biofilm-forming ability dependent on a reduced GTF activity.

Figure 5.
Biofilm formation in Streptococcus mutans UA159 wild-type and WIG− variants. The results are expressed as the mean ± standard deviations from three independent assays. Different letters indicate significant statistical differences using the Tukey–Kramer method (p < 0.05).

Figure 6.
GTF activity in the Streptococcus mutans UA159 wild-type and WIG− variants. The results are expressed as the mean ± standard deviations from three independent assays. Different letters indicate statistically significant differences using the Tukey–Kramer method (p < 0.05).
4. Discussion
The molecular basis for the appearance of WIG− strains of S. mutans is unclear. The present study showed that there were multiple alleles and a diversity in the gtfB–gtfC regions of 23 WIG− variants from S. mutans UA159. We have previously shown that several S. mutans strains, including clinical isolates, have a WIG− variant frequency of approximately 1.0×10−3 [6]. As shown in Figure 2, amplifying the gtfB–gtfC region using DNA from the wild-type strain generated 9000- and 4300-bp-long PCR products. Similar results were reported by Hazlett et al. [11], who concluded that the 9000 bp product was from the intact gtfB and gtfC, while the 4300 bp fragment was from a WIG− variant. Our results indicated the potential presence of WIG− variants in wild-type strains.
Our data also indicate that WIG− variants result from a single homologous recombination between gtfB and gtfC and that the recombination positions are inconsistent. Previously, we showed that WIG− variants arose in a RecA-dependent manner [6]. An important role of RecA is the recombination-mediated repair of damaged DNA [12]. S. mutans is exposed to various environmental stresses such as acids, nutrient limitation, antibiotics, and oxidative stress [13]. We speculated that the appearance of WIG− variants results from the repair of stress-induced DNA damage. We have previously reported an increased frequency of WIG− variants in biofilms [6]. Therefore, in this study, WIG⁻ variants were obtained from both liquid cultures and biofilms. However, no new allele type was found in the WIG− variants obtained from biofilms. Hence, there may be no relationship between the frequency of WIG− variants and allelic patterns. Future studies are needed to investigate the relationship between the type and intensity of oral environmental stress and the allelic genotypes that appear.
WIGs cause S. mutans to form three-dimensional biofilms, increasing their virulence [14,15]. In the present study, the WIG− variant lost GTF activity and consequently had a significantly lower biofilm formation ability. What are the implications of multiple allele types in the gtfB–gtfC regions of WIG− variants for the virulence expression of S. mutans? The relationship between glucan-binding proteins and water-insoluble glucans during biofilm formation may provide clues to answer this question. Glucan-binding proteins are responsible for maintaining biofilm structure by binding bacteria to extracellular glucans [16,17]. The deletion of gbpA, which encodes a glucan-binding protein in S. mutans, did not show a reduced virulence in in vivo models, despite these models losing their three-dimensional biofilm structure [16]. Hazlett et al. [11] showed that the gbpA mutant induces the appearance of WIG− variants. They speculated that the presence of WIG− variants leads to remodeling in response to changes in the biofilm structure associated with the loss of gbpA, resulting in a pathogenicity similar to that of the parental strain. Another perspective is to consider interactions with other bacteria. We have previously shown that the appearance of WIG− variants is regulated by the competence (com) system via competence-stimulating peptides [6]. The com system plays a role in interactions with other bacterial species [18]. This observation provides important insights into the oral environment adaptation and expression of virulence in S. mutans. Future studies should investigate the association between the distribution of WIG− variants in the human oral cavity and oral diseases, including dental caries. Nonetheless, the results of this study provide some useful information and will be a good reference for future research in this field.
In this study, the gtfB–gtfC region of WIG⁻ variants was sequenced in UA159 strains only, not in other strains. In the future, the allelic occurrence of the same gene region of these WIG⁻ variants should be evaluated in other S. mutans, including clinical strains.
5. Conclusions
S. mutans synthesizes insoluble glucans from sucrose by two tandemly arranged GTFs encoded by gtfB and gtfC, resulting in the formation of a strongly adhering biofilm. Naturally occurring WIG− variants in S. mutans are caused by the homologous recombination of gtfB and gtfC and have a reduced ability to form biofilms. However, the molecular basis for the emergence of WIG− variants remains unclear. Our results showed that the gtf region of WIG− variants could be classified into five allele types, including four expression patterns, owing to differences in the position of the homologous recombination site between gtfB and gtfC. To our knowledge, this is the first report on the gtfB–gtfC diversity in WIG− variants in S. mutans. The results of this study provide a molecular basis for the pathogenic expression and ecological assessment of S. mutans.
Supplementary Materials
The following supporting information can be downloaded at: https://www.mdpi.com/article/10.3390/bacteria3040025/s1, Table S1: Oligonucleotide primers used in this study.
Author Contributions
Conceptualization, M.K. and N.N.; methodology, M.K., N.N., T.N.-N. and H.S.; validation, M.K. and N.N.; formal analysis, M.K.; investigation, M.K. and N.N.; resources, M.K. and N.N.; data curation, M.K.; writing—original draft preparation, M.K. and N.N.; writing—review and editing, N.N.; visualization, M.K.; project administration, N.N.; funding acquisition, M.K. and N.N. All authors have read and agreed to the published version of the manuscript.
Funding
This work was partially funded by a Grant-in-Aid for the Development of Scientific Research (No. 22K02143) from the Ministry of Education, Science, and Culture of Japan. This work was partially funded by the Sasakawa Scientific Research Grant from the Japan Science Society.
Institutional Review Board Statement
Not applicable.
Informed Consent Statement
Not applicable.
Data Availability Statement
The original contributions presented in the study are included in the article/Supplementary Materials. Further inquiries could be sent to the corresponding authors.
Conflicts of Interest
The authors declare no conflicts of interest. The funders had no role in the study design, collection, analyses, or interpretation of data, writing of the manuscript, or decision to publish the results.
References
- Lemos, J.A.; Palmer, S.R.; Zeng, L.; Wen, Z.T.; Kajfasz, J.K.; Freires, I.A.; Abranches, J.; Brady, L.J. The biology of Streptococcus mutans. Microbiol. Spectr. 2019, 7, 10–128. [Google Scholar] [CrossRef] [PubMed]
- Hoshino, T.; Fujiwara, T.; Kawabata, S. Evolution of cariogenic character in Streptococcus mutans: Horizontal transmission of glycosyl hydrolase family 70 genes. Sci. Rep. 2012, 2, 518. [Google Scholar] [CrossRef] [PubMed]
- Paes Leme, A.F.; Koo, H.; Bellato, C.M.; Bedi, G.; Cury, J.A. The role of sucrose in cariogenic dental biofilm formation—New insight. J. Dent. Res. 2006, 85, 878–887. [Google Scholar] [CrossRef] [PubMed]
- Ueda, S.; Kuramitsu, H.K. Molecular basis for the spontaneous generation of colonization-defective mutants of Streptococcus mutans. Mol. Microbiol. 1988, 2, 135–140. [Google Scholar] [CrossRef] [PubMed]
- Inagaki, S.; Fujita, K.; Takashima, Y.; Nagayama, K.; Ardin, A.C.; Matsumi, Y.; Matsumoto-Nakano, M. Regulation of recombination between gtfB/gtfC genes in Streptococcus mutans by recombinase A. Sci. World J. 2013, 2013, 405075. [Google Scholar] [CrossRef] [PubMed]
- Narisawa, N.; Kawarai, T.; Suzuki, N.; Sato, Y.; Ochiai, K.; Ohnishi, M.; Watanabe, H.; Senpuku, H. Competence-dependent endogenous DNA rearrangement and uptake of extracellular DNA give a natural variant of Streptococcus mutans without biofilm formation. J. Bacteriol. 2011, 193, 5147–5154. [Google Scholar] [CrossRef] [PubMed][Green Version]
- Narisawa, N. Development, characterization and ecological implications of a smooth colony variant of biofilm-forming cariogenic Streptococcus mutans. J. Oral Biosci. 2010, 52, 245–251. [Google Scholar] [CrossRef]
- Nomura, R.; Nakano, K.; Nemoto, H.; Fujita, K.; Inagaki, S.; Takahashi, T.; Taniguchi, K.; Takeda, M.; Yoshioka, H.; Amano, A.; et al. Isolation and characterization of Streptococcus mutans in heart valve and dental plaque specimens from a patient with infective endocarditis. J. Med. Microbiol. 2006, 55, 1135–1140. [Google Scholar] [CrossRef] [PubMed]
- Nakamura, T.; Iwabuchi, Y.; Hirayama, S.; Narisawa, N.; Takenaga, F.; Nakao, R.; Senpuku, H. Roles of membrane vesicles from Streptococcus mutans for the induction of antibodies to glucosyltransferase in mucosal immunity. Microb. Pathog. 2020, 149, 104260. [Google Scholar] [CrossRef] [PubMed]
- Goto, I.; Saga, S.; Ichitani, M.; Kimijima, M.; Narisawa, N. Investigation of components in roasted green tea that inhibit Streptococcus mutans biofilm formation. Foods 2023, 12, 2502. [Google Scholar] [CrossRef] [PubMed]
- Hazlett, K.R.; Michalek, S.M.; Banas, J.A. Inactivation of the gbpA gene of Streptococcus mutans increases virulence and promotes in vivo accumulation of recombinations between the glucosyltransferase B and C Genes. Infect. Immun. 1998, 66, 2180–2185. [Google Scholar] [CrossRef] [PubMed]
- Del Val, E.; Nasser, W.; Abaibou, H.; Reverchon, S. RecA and DNA recombination: A review of molecular mechanisms. Biochem. Soc. Trans. 2019, 47, 1511–1531. [Google Scholar] [CrossRef] [PubMed]
- Lemos, J.A.; Burne, R.A. A model of efficiency: Stress tolerance by Streptococcus mutans. Microbiology 2008, 154, 3247–3255. [Google Scholar] [CrossRef] [PubMed]
- Bowen, W.H.; Koo, H. Biology of Streptococcus mutans-derived glucosyltransferases: Role in extracellular matrix formation of cariogenic biofilms. Caries Res. 2011, 45, 69–86. [Google Scholar] [CrossRef] [PubMed]
- Lynch, D.J.; Fountain, T.L.; Mazurkiewicz, J.E.; Banas, J.A. Glucan-binding proteins are essential for shaping Streptococcus mutans biofilm architecture: S. mutans gbps and biofilm architecture. FEMS Microbiol. Lett. 2007, 268, 158–165. [Google Scholar] [CrossRef] [PubMed]
- Hazlett, K.R.; Mazurkiewicz, J.E.; Banas, J.A. Inactivation of the gbpA gene of Streptococcus mutans alters structural and functional aspects of plaque biofilm which are compensated by recombination of the gtfB and gtfC genes. Infect. Immun. 1999, 67, 3909–3914. [Google Scholar] [CrossRef] [PubMed]
- Banas, J.A.; Vickerman, M.M. Glucan-binding proteins of the oral Streptococci. Crit. Rev. Oral Biol. Med. 2003, 14, 89–99. [Google Scholar] [CrossRef] [PubMed]
- Tamura, S.; Yonezawa, H.; Motegi, M. Inhibiting effects of Streptococcus salivarius on competence-stimulating peptide-dependent biofilm formation by Streptococcus mutans. Oral Microbiol. Immunol. 2009, 24, 152–161. [Google Scholar] [CrossRef] [PubMed]
Disclaimer/Publisher’s Note: The statements, opinions and data contained in all publications are solely those of the individual author(s) and contributor(s) and not of MDPI and/or the editor(s). MDPI and/or the editor(s) disclaim responsibility for any injury to people or property resulting from any ideas, methods, instructions or products referred to in the content. |
© 2024 by the authors. Licensee MDPI, Basel, Switzerland. This article is an open access article distributed under the terms and conditions of the Creative Commons Attribution (CC BY) license (https://creativecommons.org/licenses/by/4.0/).